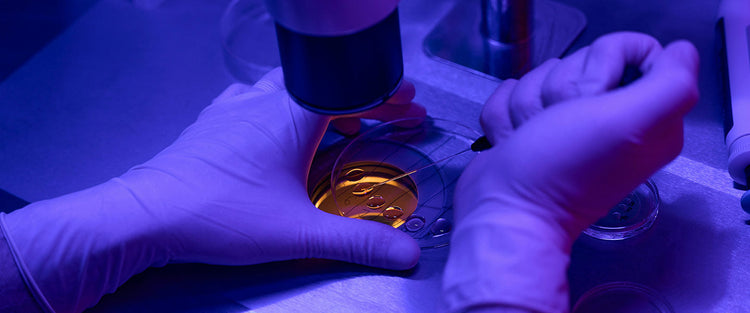
ivf embryo under a microscope

21 October 2025
What I Would Do To Improve Egg Quality – as a Fertility Nutritionist.
Jen, a qualified nutritionist, outlines what she would do to improve egg qual...

21 October 2025

01 September 2025

07 August 2025

03 June 2025

06 May 2025
29 April 2025